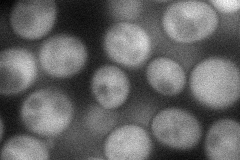
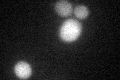

View description
Ubiquitin-conjugating enzyme that mediates selective degradation of short-lived, abnormal, or excess proteins, including histone H3; central component of the cellular stress response; expression is heat inducible
Localization:
Intensity:
Fold change:
Significance:
-
C’ GFP library in SD

cytosol29.31 -
N' NOP1pr-GFP in SD
cytosol65.4687 -
N' TEF2pr-mCherry in SD

missing0 -
N' NATIVEpr-GFP in SD

missing0 -
N' TEF2pr-VC and Cyto-VN in SD

#N/A0 -
C’ GFP library in SD+DTT
cytosol22.970.78No -
C’ GFP library in SD+H2O2

cytosol30.81.05No -
C’ GFP library in Starvation Media

cytosol64.832.21Yes -
C’ GFP library on the background of Pup2-DaMP

cytosol -
C’ GFP library on the background of CCT mutant

cytosol28.85550.984337No
